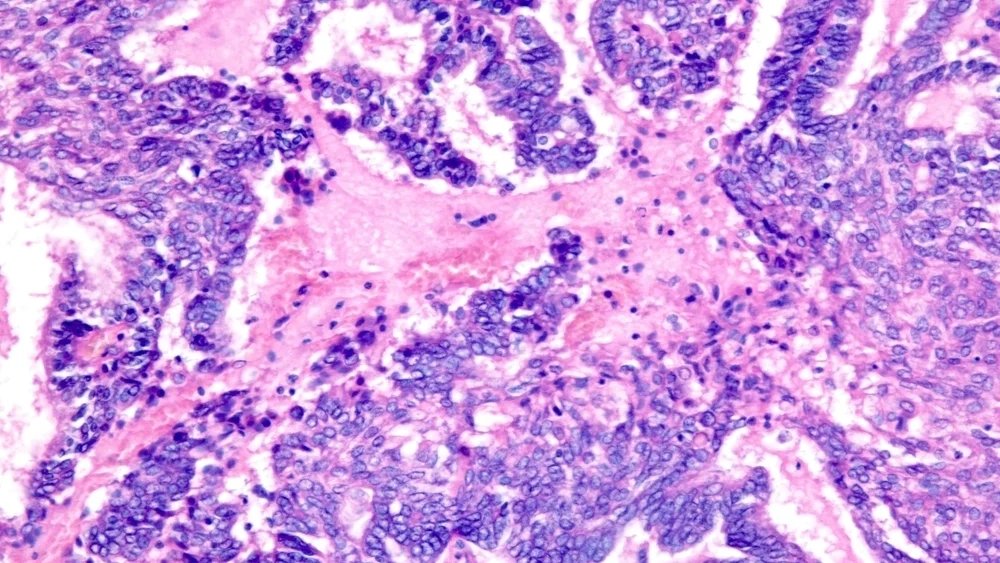

في بعض مناطق العالم، يتم تطهير الدم المتبرع به أو مكونات الدم مثل الصفائح الدموية بالأشعة فوق البنفسجية والريبوفلافين، المعروف أيضًا باسم فيتامين ب2، قبل نقله إلى المرضى. تتيح لك هذه الطريقة تحييد العديد من الفيروسات والبكتيريا والطفيليات. يريد فريق من الباحثين استخدام هذا الإجراء لمحاربة السرطان عن طريق تعطيل الخلايا السرطانية ثم إعادة إدخالها إلى الجسم لمحاولة تحفيز استجابة مناعية مفيدة.
وقد تم بالفعل اختبار هذا النهج على الفئران والكلاب، وستبدأ المرحلة الأولى من التجارب السريرية على المرضى الذين يعانون من سرطان المبيض المتكرر في المستقبل القريب، حسبما كتبت الخدمة الإخبارية. علوم.
وتعتمد هذه الطريقة على حقيقة أن الريبوفلافين يرتبط بالحمض النووي والحمض النووي الريبوزي (RNA)، وعند تعريضه للأشعة فوق البنفسجية، فإنه يدمر المادة الوراثية للفيروسات والبكتيريا والطفيليات، مما يحرمها من القدرة على التكاثر. جاءت فكرة الاستخدام لعلاج الأورام من الكيميائي راي جودريتش في جامعة ولاية كولورادو. ولاحظ أنه بعد العلاج بالأشعة فوق البنفسجية، تفقد الخلايا قدرتها على الانقسام، لكنها تحتفظ ببنيتها.
ووفقاً لخطته، يمكن تحويل الخلايا السرطانية “المعطلة” لدى المريض إلى لقاح شخصي: فهي لا تشكل ورماً، ولكنها تحتوي على جميع المستضدات الجديدة – بروتينات الورم الفريدة التي يتعرف عليها الجهاز المناعي.
يمكن لهذا النهج أن يحل إحدى المشاكل الرئيسية للقاحات السرطان – الحاجة إلى التخمين مقدمًا أي المستضدات ستكون أكثر فعالية. إن تضمين الخلايا الكاملة يزيد من فرص النجاح.
ومع ذلك، لا تزال هناك شكوك في المجتمع العلمي. يتذكر عالم المناعة لورانس فونغ من مركز فريد هاتشينسون للسرطان (الولايات المتحدة الأمريكية) أن اللقاحات التي تعتمد على خلايا ورم كاملة قد تم تطويرها منذ عقود ولم تظهر نتائج مقنعة بعد. ويشير عالم المناعة أوليفر فين من جامعة بيتسبرغ أيضًا إلى أن الأورام تقمع الاستجابة المناعية بشكل فعال حتى عندما يتم تنشيطها.
سيتم إجراء المرحلة الأولى من التجارب السريرية في مركز مدينة الأمل الطبي (كاليفورنيا). وتخطط الدراسة لتشمل ثمانية مرضى يعانون من سرطان المبيض المتكرر. بعد الاستئصال الجراحي للورم، ستتم معالجة الخلايا بالريبوفلافين والأشعة فوق البنفسجية، ممزوجة بمادة مساعدة محفزة للمناعة، ويتم إعطاؤها على ثلاث جرعات من اللقاح. الهدف الرئيسي هو تقييم السلامة والاستجابة المناعية.
اشترك واقرأ “العلم” في
برقية
تنويه من موقعنا
تم جلب هذا المحتوى بشكل آلي من المصدر:
yalebnan.org
بتاريخ: 2026-01-03 08:35:00.
الآراء والمعلومات الواردة في هذا المقال لا تعبر بالضرورة عن رأي موقعنا والمسؤولية الكاملة تقع على عاتق المصدر الأصلي.
ملاحظة: قد يتم استخدام الترجمة الآلية في بعض الأحيان لتوفير هذا المحتوى.